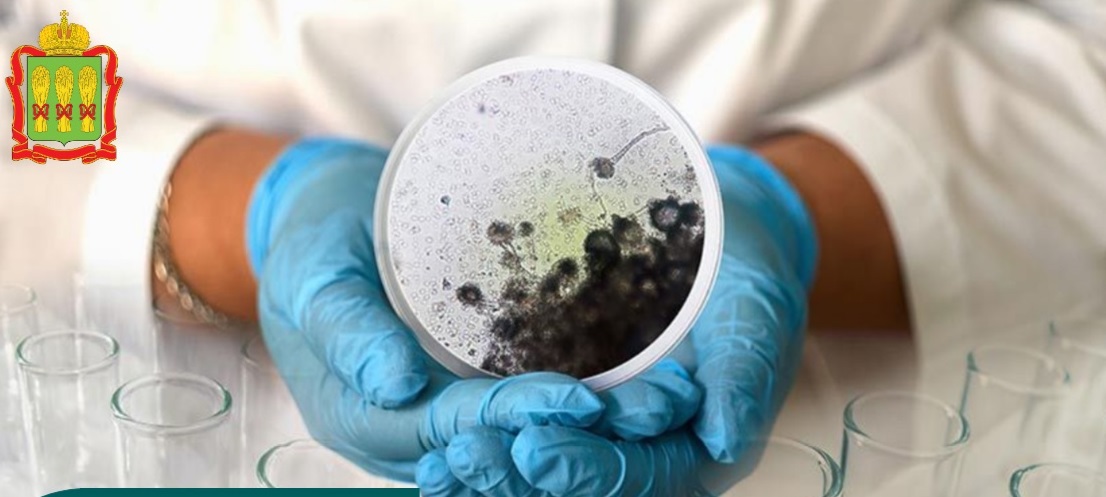
Пензенцам рассказали о страшной грибковой инфекции, споры которой повсюду

1 февраля, мир отмечает Всемирный день аспергиллеза. Цель – привлечь внимание к этому коварному заболеванию и поддержать пациентов, столкнувшихся с ним. Аспергиллез – это инфекция, вызываемая вездесущими грибами рода Aspergillus. Их споры постоянно присутствуют в воздухе, и мы ежедневно их вдыхаем. Однако здоровый иммунитет успешно справляется с этой угрозой.
Опасность аспергиллеза возникает, когда иммунная система ослаблена. В группу риска входят люди с хроническими заболеваниями легких, такими как астма, ХОБЛ, муковисцидоз, саркоидоз и туберкулез. Также подвержены аспергиллезу пациенты с ВИЧ/СПИДом, перенесшие COVID-19, проходящие химиотерапию, а также после трансплантации органов или стволовых клеток.
Заболевание может протекать бессимптомно, и единственным способом его обнаружения в таком случае является рентген грудной клетки. Иногда единственными признаками являются боль в груди и кровохарканье. При быстром развитии инфекции в легких возникают такие симптомы, как боль в груди, кашель, затрудненное дыхание и лихорадка. Без лечения агрессивные формы аспергиллеза могут привести к летальному исходу из-за легочного кровотечения или обширного поражения органов.
Лечение менее агрессивных форм обычно включает противогрибковые препараты и стероиды. В случае инвазивного аспергиллеза может потребоваться хирургическое вмешательство для удаления очага инфекции в дополнение к медикаментозной терапии. Профилактика заболевания включает в себя защиту групп риска от контакта с плесенью и профилактическое назначение противогрибковых препаратов пациентам с ослабленным иммунитетом.